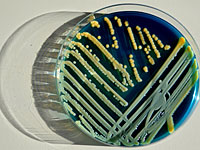
В больнице

Здоровье
adv_09 rimma_dw_d
adv_10 rimma_dw_m
adv_11 ca_instrip_direct
О полезных свойствах китайского чая и женьшеня. Рассказывает эксперт Юлия Павловская
Редакция NEWSru.co.il продолжает публикации о полезных свойствах и особенностях китайского чая. Наша собеседница – Юлия Павловская, одна из ведущих израильских экспертов по китайскому чаю, работающая в компании Time For Tea.
adv_12 ca_instrip_direct
Здоровье ::
23 Октября 2016 г.